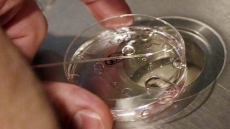
Trying For Test-tube Baby? Moms' Risks Are Rare, Include Over-stimulating Ovaries

Researchers have discovered how to create a more effective nicotine vaccine that could help smokers and even drug addicts quit.
With an effective nicotine vaccine, people may be less motivated to relapse because the brain's reward system could no longer react to nicotine.
The scientists from The Scripps Research Institute (TSRI) in the US first found out why a promising nicotine vaccine failed in clinical trials a few years ago.
"Our study provides new hope that one could make a nicotine vaccine that succeeds in clinical trials," said Kim Janda, professor of chemistry at TSRI.
The problem with the previous nicotine vaccine, which only worked in 30 percent of patients, was that it did not single out the most common form of nicotine for attack.
Nicotine has two forms that look like mirror images of each other -- one is a "right-handed" version and the other a "left-handed" version.
Even though 99 percent of the nicotine found in tobacco is the left-handed version, the previous vaccine elicited antibodies against both.
In the new study, the researchers elicited a more robust antibody response by creating a vaccine from only left-handed nicotine derivatives called haptens.
To do this, they prepared haptens as a 50-50 mixture and as pure right-handed or pure left-handed versions of nicotine, so they could use the two versions together or separately.
They tested both versions and the 50-50 mix in rat models, injecting the rats three times over 42 days.
The researchers analysed blood from the three experimental groups and found that the left-handed hapten elicited a much more effective immune response.
"This shows that future vaccines should target that left-handed version," said Jonathan Lockner, research associate in the Janda lab and first author of the new paper.
The study was published in the Journal of Medicinal Chemistry.